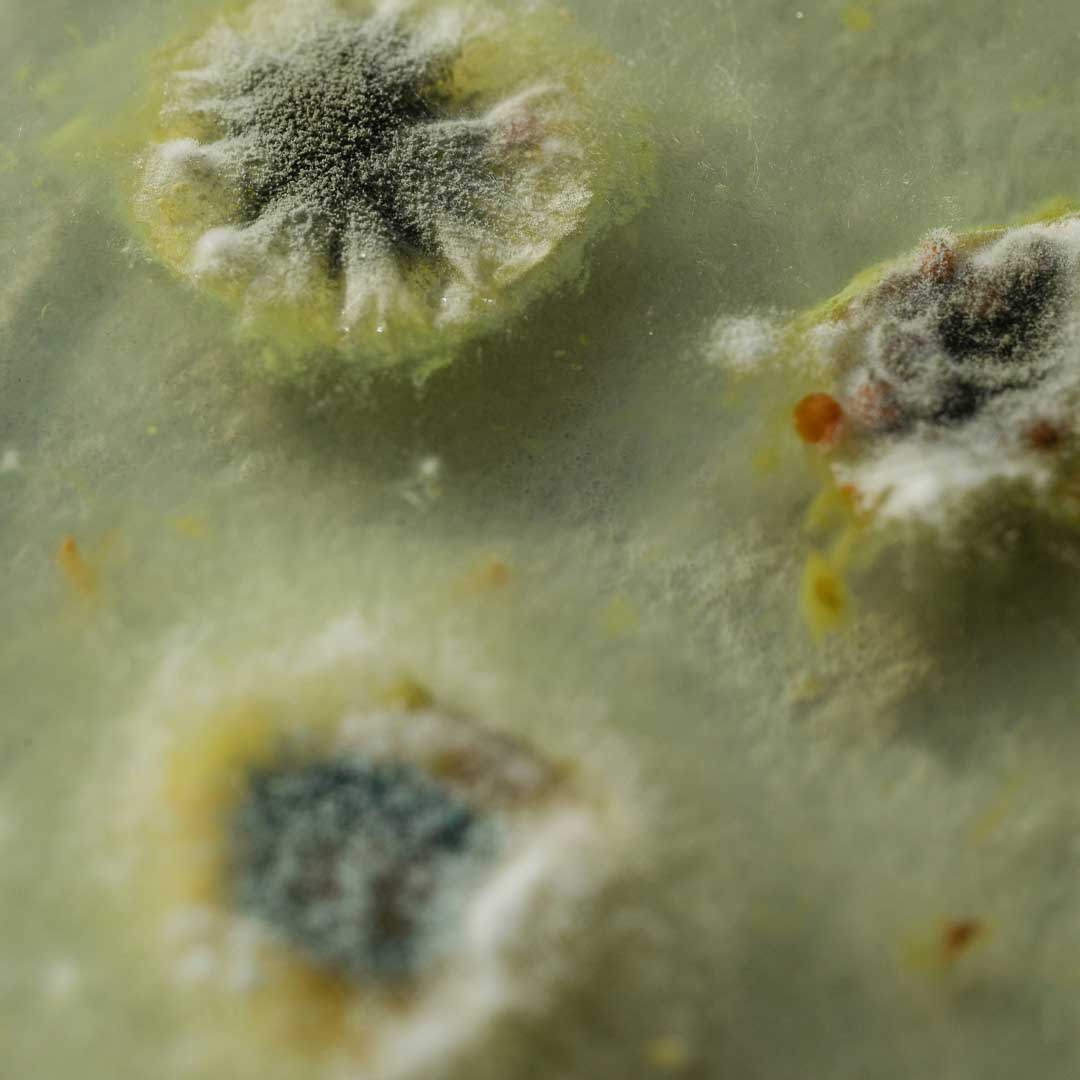
mould testing for your home or business

Mould is more than just an unsightly nuisance — it’s a serious health and structural concern for homes and commercial buildings. While minor patches can sometimes be managed by homeowners, many cases require professional inspection and removal to ensure safety. Swipe Contracting specializes in mould removal services in BC, providing expert remediation, air quality testing, and long-term solutions for both residential and commercial properties.
Understanding mould, how it grows, and when professional intervention is necessary can help protect your health, property, and peace of mind.
What Is Mould and How Does It Grow?
Mould is a type of fungus that thrives in damp, humid, or poorly ventilated areas. It can grow on virtually any surface, including:
- Walls and ceilings
- Carpets and flooring
- Insulation and drywall
- Wood surfaces
Common causes of mould growth include water leaks, flooding, high humidity, and condensation. Even small leaks or moisture build-up behind walls can create ideal conditions for mould growth.
Signs of Mould in Your Property

Mould can be visible or hidden. Some common signs include:
- Black, green, or white patches on walls, ceilings, or floors
- Musty or damp odours
- Discoloration or warping of surfaces
- Health symptoms such as coughing, sneezing, or respiratory irritation
Tip: If you notice these signs, it’s important not to ignore them. Early detection can prevent serious structural damage and long-term health issues.
Health Risks Associated with Mould Exposure
Exposure to mould can have varying health effects depending on the individual and the type of mould present. Common health risks include:
- Respiratory issues (asthma, bronchitis, shortness of breath)
- Allergic reactions (sneezing, runny nose, red eyes, skin irritation)
- Chronic fatigue and headaches in sensitive individuals
- Severe complications for infants, elderly individuals, or those with compromised immune systems
Black mould (Stachybotrys chartarum) is particularly concerning and requires professional removal due to its toxic spores.
Why DIY Mould Removal Can Be Risky
Attempting to remove mould without proper equipment and training can:
- Spread spores to other areas of the property
- Cause incomplete removal, allowing regrowth
- Expose homeowners to serious health risks
- Damage property if incorrect cleaning methods are used
For these reasons, professional mould remediation is highly recommended, especially for extensive growth or high-risk areas.
Professional Mould Inspection and Removal

Swipe Contracting provides a full range of professional mould services, including:
- Comprehensive Inspection: Identifying visible and hidden mould using industry-standard techniques and tools.
- Air Quality Testing: Measuring spores and contaminants to assess the level of risk.
- Containment & Safety Measures: Ensuring spores do not spread during removal.
- Removal & Remediation: Safe and thorough cleaning of affected areas using certified methods.
- Prevention Guidance: Recommendations to prevent future mould growth, including ventilation, moisture control, and structural fixes.
Professional removal ensures that the mould is completely eliminated and reduces the risk of recurrence, protecting both your health and property value.
When to Call the Experts
You should contact Swipe Contracting immediately if:
- Mould covers more than 10 square feet
- You notice persistent musty odours
- There has been flooding or significant water damage
- Household members experience ongoing health issues linked to indoor air
Early intervention can save thousands in property repairs and prevent long-term health complications.
Preventing Mould in Your Property

Preventive measures include:
- Fixing leaks promptly
- Maintaining proper ventilation
- Using dehumidifiers in damp areas
- Regular inspections, especially in basements, attics, and crawl spaces
For ongoing safety, consider professional air quality testing to catch issues before they become visible.
Mould is a serious concern for any home or commercial property, but it doesn’t have to be a long-term problem. With early detection, professional remediation, and proper preventive measures, you can protect your property and your family’s health.
Request a Mould Inspection or Call Swipe Contracting Today for professional mould removal services in British Columbia!
